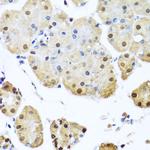
NuMA Antibody in Immunohistochemistry (Paraffin) (IHC (P))

Search
Invitrogen
NuMA Polyclonal Antibody
{{$productOrderCtrl.translations['antibody.pdp.commerceCard.promotion.promotions']}}
{{$productOrderCtrl.translations['antibody.pdp.commerceCard.promotion.viewpromo']}}
{{$productOrderCtrl.translations['antibody.pdp.commerceCard.promotion.promocode']}}: {{promo.promoCode}} {{promo.promoTitle}} {{promo.promoDescription}}. {{$productOrderCtrl.translations['antibody.pdp.commerceCard.promotion.learnmore']}}

Please note: We are reviewing Western blot images included in the antibody testing data in our catalog, including those provided by third parties. Unless expressly labeled or annotated as “raw-unedited”, Western blot images included in the antibody testing data in our catalog may have been edited, optimized or otherwise adjusted for presentation.
产品信息
PA5-87448
种属反应
宿主/亚型
分类
类型
抗原
偶联物
形式
浓度
规格
纯化类型
保存液
内含物
保存条件
运输条件
RRID
产品详细信息
Immunogen sequence: MTLHATRGAA LLSWVNSLHV ADPVEAVLQL QDCSIFIKII DRIHGTEEGQ QILKQPVSER LDFVCSFLQK NRKHPSSPEC LVSAQKVLEG SELELAKMTM LLLYHSTMSS KSPRDWEQFE YKIQAELAVI LKFVLDHEDG LNLNEDLENF LQKAPVPSTC SSTFPEELSP PSHQAKREIR FLELQKVASS SSGNNFLSGS PASPMGDILQ TPQFQMRRLK KQLADERSNR DELELELAEN RKLLTEKDAQ IAMMQQRIDR LALLNEKQAA SPLEPKELEE LRDKNESLTM RLHETLKQCQ DLKTEKSQM; Positive Samples: HeLa, Mouse kidney; Cellular Location: Chromosome, Cytoplasm, Nucleus matrix, cytoskeleton, spindle pole
靶标信息
NuMA (nuclear mitotic apparatus) is a long coil-coiled protein that plays a role in the interphase and mitosis phases of a cell cycle. In interphase, it has been hypothesized to play a structural role in the nucleoskeleton that may be important in nuclear organization and functions. During mitosis, it is associated with spindle microtubule organization and chromosome positioning.
仅用于科研。不用于诊断过程。未经明确授权不得转售。
篇参考文献 (0)
生物信息学
蛋白别名: Nuclear mitotic apparatus protein; Nuclear mitotic apparatus protein 1; NuMA protein
基因别名: 6720401E04Rik; AA764025; AL022610; AU014979; Numa1
UniProt ID: (Mouse) E9Q7G0
Entrez Gene ID: (Rat) 308870, (Mouse) 101706




